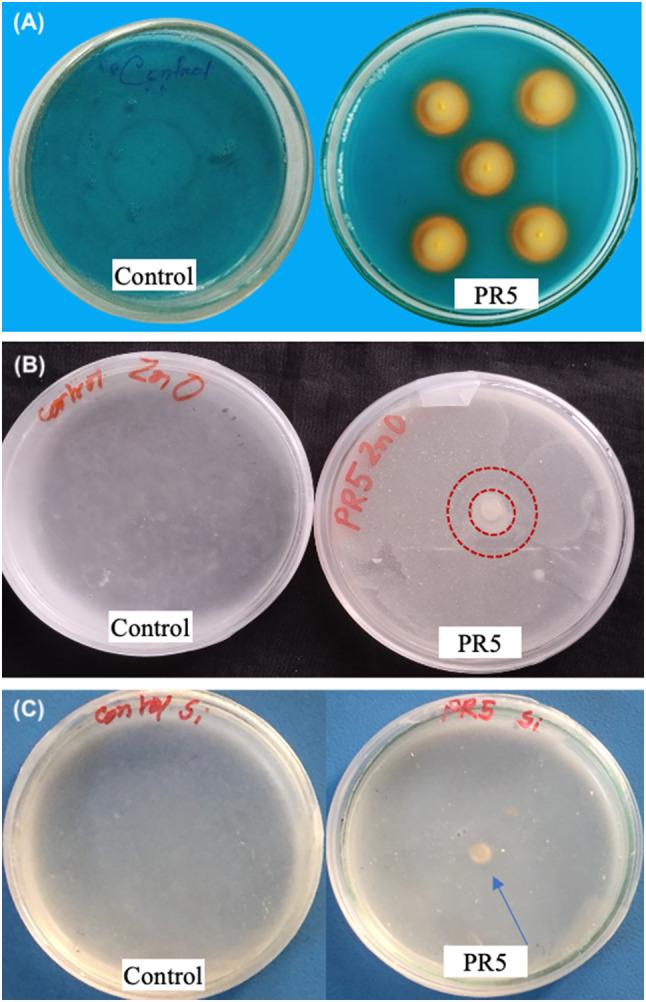
https://cdn.ncbi.nlm.nih.gov/pmc/blobs/51ba/11523849/ce1a52c347fc/12870_2024_5649_Fig1_HTML.jpg

细菌内生菌假单胞菌 PR5 通过各种应用方法提高水稻(Oryza sativa L.)的生长、养分积累和产量。
Bacterial endophyte Pseudomonas mosselii PR5 improves growth, nutrient accumulation, and yield of rice (Oryza sativa L.) through various application methods.
机构信息
Department of Agricultural Chemistry, Bangladesh Agricultural University, Mymensingh, Bangladesh.
Institute of Biotechnology and Genetic Engineering, Bangabandhu Sheikh Mujibur Rahman Agricultural University, Gazipur, Bangladesh.
出版信息
BMC Plant Biol. 2024 Oct 30;24(1):1030. doi: 10.1186/s12870-024-05649-6.
BACKGROUND
Pseudomonas spp. have drawn considerable attention due to their rhizospheric abundance and exceptional plant growth-promoting attributes. However, more research is needed on the optimal application methods of Pseudomonas mosselii for rice growth, nutrient accumulation, and yield improvement. This research explored the application of the endophytic bacterium P. mosselii PR5 on rice cultivar BRRI dhan29 with four treatments: control, seedling priming, root drenching, and bacterial cell-free culture (CFC) foliar application.
RESULTS
PR5 led to better rice growth, improved nutrient acquisition, and higher yields compared to the control, regardless of the application method used. The highest results in fresh weight of root (146.93 g/pot), shoot (758.98 g/pot), and flag leaf (7.88 g/pot), dry weight of root (42.16 g/pot), shoot (97.32 g/pot), and flag leaf (2.69 g/pot), and grains/panicle (224.67), were obtained from seedling priming treatment, whereas root drenching resulted in maximum plant height (105.67 cm), root length (49.0 cm), tillers/pot (23.7), and panicles/pot (17.67). In all three application methods, rice grain yield per pot was higher in PR5 inoculated treatments, compared to the control. The amount of P, Mg and Zn in the shoot and N, P, Ca, Mg and Si content in the flag leaf was significantly increased along with effective suppression of naturally occurring blast disease in bacterial CFC foliar application, validated by multivariate analysis.
CONCLUSION
Our results indicated that rice seedlings priming with PR5 improved rice growth, yield and nutrient uptake, whereas CFC foliar application significantly increased the concentration of most nutrients in the rice plant and suppressed the naturally occurring rice blast disease. This research highlights the significant potential of P. mosselii PR5 in enhancing rice growth, yield, and nutrient uptake, particularly through seedling priming and CFC foliar application methods.
背景
假单胞菌由于其在根际的丰富度和出色的植物促生长特性而引起了相当大的关注。然而,对于假单胞菌 mosselii 用于水稻生长、养分积累和产量提高的最佳应用方法,还需要更多的研究。本研究探索了内生细菌 P. mosselii PR5 在水稻品种 BRRI dhan29 上的应用,采用了 4 种处理方法:对照、种子预处理、根部灌洗和细菌无细胞培养(CFC)叶面喷施。
结果
与对照相比,无论采用哪种应用方法,PR5 都能促进水稻生长,改善养分吸收,提高产量。种子预处理处理的根鲜重(146.93 g/盆)、茎叶鲜重(758.98 g/盆)和旗叶鲜重(7.88 g/盆)、根干重(42.16 g/盆)、茎叶干重(97.32 g/盆)和旗叶干重(2.69 g/盆)以及穗粒数(224.67)最高,而根部灌洗则使株高(105.67 cm)、根长(49.0 cm)、每盆分蘖数(23.7)和每盆穗数(17.67)最高。在所有三种应用方法中,与对照相比,接种 PR5 的水稻穗粒产量均有所提高。通过多元分析验证,在 CFC 叶面喷施中,有效抑制了自然发生的稻瘟病,同时还显著增加了茎叶中的 P、Mg 和 Zn 以及旗叶中的 N、P、Ca、Mg 和 Si 含量。
结论
我们的结果表明,PR5 对水稻幼苗进行预处理可促进水稻生长、产量和养分吸收,而 CFC 叶面喷施可显著提高水稻植株中大多数养分的浓度,并抑制自然发生的稻瘟病。本研究强调了 P. mosselii PR5 在促进水稻生长、产量和养分吸收方面的巨大潜力,特别是通过种子预处理和 CFC 叶面喷施方法。